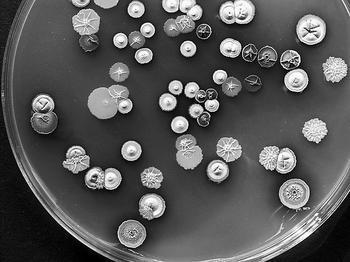

- 基因药物

基因药物
诞生
基因药物的出现与基因工程技术的发展息息相关,基因工程技术是现代生物技术的主体。基因工程是通过对核酸分子的插入、拼接和重组而实现遗传物质的重组,再借助病毒、细菌、质粒或其他载体,将目的基因转移到新的宿主细胞,并使目的基因在新的宿主细胞内复制和表达的技术。基因是DNA分子上的一个特定的片断,因此基因工程又称DNA分子水平上的生物工程。
基因药物的出现与基因工程技术的发展息息相关,基因工程技术是现代生物技术的主体。基因工程是通过对核酸分子的插入、拼接和重组而实现遗传物质的重组,再借助病毒、细菌、质粒或其他载体,将目的基因转移到新的宿主细胞,并使目的基因在新的宿主细胞内复制和表达的技术。基因是DNA分子上的一个特定的片断,因此基因工程又称DNA分子水平上的生物工程。
现代遗传学家认为,基因是DNA(脱氧核糖核酸)分子上具有遗传效应的特定核苷酸序列的总称,是具有遗传效应的DNA分子片段。基因位于染色体上,并在染色体上呈线性排列。基因不仅可以通过复制把遗传信息传递给下一代,还可以使遗传信息得到表达。不同人种之间头发、肤色、眼睛、鼻子等不同,是基因差异所致。
人类只有一个基因组,大约有5-10万个基因。人类基因组计划是美国科学家于1985年率先提出的,旨在阐明人类基因组30亿个碱基对的序列,发现所有人类基因并搞清其在染色体上的位置,破译人类全部遗传信息,使人类第一次在分子水平上全面地认识自我。计划于1990年正式启动,这一价值30亿美元的计划的目标是,为30亿个碱基对构成的人类基因组精确测序,从而最终弄清楚每种基因制造的蛋白质及其作用。打个比方,这一过程就好像以步行的方式画出从北京到海'>上海的路线图,并标明沿途的每一座山峰与山谷。虽然很慢,但非常精确。
随着人类基因组逐渐被破译,一张生命之图将被绘就,人们的生活也将发生巨大变化。基因药物已经走进人们的生活,利用基因治疗更多的疾病不再是一个奢望。因为随着我们对人类本身的了解迈上新的台阶,很多疾病的病因
将被揭开,药物就会设计得更好些,治疗方案就能“对因下药”,生活起居、饮食习惯有可能根据基因情况进行调整,人类的整体健康状况将会提高,二十一世纪的医学基础将由此奠定。
其主要任务是有关基因的分离、合成、切断、重组、转移和表达等。近20年来,DNA重组技术与基因治疗技术发展十分迅速,已进入实用化阶段。DNA重组技术的进展,大大增进了人们对生命本质的认识,包括对疾病遗传基础的了解。今后对癌症的发生机制,疾病的遗传特性,免疫系统的功能,代谢衰竭性疾病的病因和大脑功能的物化机理获得进一步的了解,从而诞生对遗传性疾病和重大疑难疾病治疗的新途径。基因药物就是基因工程技术发展的产物。它的出现将使现有的医疗实践发生革命性的改变,使一切疾病变得可为人们征服。人们渴望的远离疾病,而拥有健康体魄的时代正向我们走来。
发展
 基因药物随着基因工程技术的发展而发展,大致经历了3个阶段:
基因药物随着基因工程技术的发展而发展,大致经历了3个阶段:
△其一是细菌基因工程。它是通过原核细胞(常用大肠杆菌)来表达目的基因的,这个工程相当复杂,成本和工艺上也有许多问题。
△其二是细胞基因工程。细胞基因工程也有不足之处,因为人或哺乳动物细胞培养的条件相当苛刻,成本太高,这样就限制了细胞基因工程的发展。
△其三是转基因动物。即把人或哺乳动物的某种基因导入到哺乳动物的受精卵里,每个细胞里都带有导入的基因,而且能稳定地遗传到下一代。这样一种新的个体,称为转基因动物。转基因动物的问世,为利用新的基因工程手段获得低成本高活性的基因药物开辟了一条新的途径。
与动物药厂
■1,概念
科学家发现,人类的很多先天性疾病是由于缺乏与之相应的基因造成的,而靠现在一般的药物很难治愈,如将正常人的正常基因片段导入到动物体内,让这种基因在哺乳动物体内表达,就可从该动物分泌的乳汁或者其他组织提取获得具有活性的基因药物,用于治疗该基因缺损造成的疾病。这种通过转基因动物获取药物的方法称为动物药厂。
动物药厂改变了人们对药厂的印象。它看起来更像是一个牧场。在这里,成群的转基因牛羊在绿色的草地上吃草,表面看,它们与普通牛羊没有差异,然而,它们体内分泌的乳汁是能给人类治病的药品,这些产乳量高的动物,就相当于一座大型的药物工厂,以它们廉价的乳汁,为人类提供着大量的所需要的珍贵药物。
■2,经济意义
据专家预测,下世纪疾病的基因治疗将大规模地从试验进入临床应用。届时,利用生物技术生产的药物将大量问世,生物制药业将成为21世纪发展最快的高科技产业之一。生物高技术医药工业虽具有强投资、长周期、高风险的特点,但一经产业化就会带来高额利润,与传统医药产业相比、动物药厂更具有投资少、效益高、无公害等优点。
医学遗传家曾益滔介绍,做细菌基因工程需要很大的车间发酵;做细胞工程药物也需要很多昂贵的设备来培养细胞,而若用转基因动物,就只要饲养,动物乳汁便可源源不断地产出药品。
现在研制一种新药,一般需要20年——30年,即使科技再发展,也很难低于10年——15年,转基因羊周期一般是18周,牛也只需2年——3年,而效益更是惊人。如荷兰金发马公司用转基因牛生产的一种乳铁蛋白,制成奶粉具有转铁、抗菌等功能,预计每年这一营养奶粉销售额是50亿美元。
1998年2月上海医学遗传研究所试验成功的转基因山羊所表达的“凝血因子”如进入工业生产也将具有惊人的产值。据美国资料统计,过去凝血因子Ⅶ都是从献血的血源中提取的,全美国这方面的病人一年需求约为120g左右,这120g得从120万升的血浆中提取,以每人献血200ml计,就需要600万个献血者提供血浆。若改用转基因牛来生产,只需1.2头牛产的牛乳即可满足。
转基因动物带来的这场生物医药革命,不仅产生了巨大的经济效益,而且还使人们传统的医疗方式发生变化,人们可以一边喝着鲜美的牛奶,一边达到了治病的目的,这个质的变化不能不令人心动。
成就
基因重组技术取得了一个个丰硕成果。1978年合成了人工胰岛素,1979年实现了生长激素基因在大肠杆菌中的表达,1982年研制成功了人工干扰素,基因制药从此走上了产业化道路。但是,目前的基因药物是通过基因重组技术培育大肠杆菌和动物细胞来制造的,而大肠杆菌这类低等生物是不可能生产出结构复杂的药物,动物细胞培养的成本又太高。所以,利用基因重组与移植技术来培育转基因动物生产药物便应运而生了在利用转基因动物提取药物方面,英国科学家首开先河。1997年年底,英国PPL治疗学公司率先利用克隆"多利"所采用的"细胞核转变"法,培育出200头携带人体基因的绵羊,并成功地从奶汁中提取了α-1抗胰蛋白酶。这是科学家首次从遗传工程培育的绵羊的奶中,提取可用于治疗人类疾病的药物成分,为建立"动物药厂" 打下了基础。随后,芬兰科学家将人体的促红细胞生长素基因,植入乳牛的受精卵中,创造了一种能生产出促红细胞生长素的乳牛。从理论上说,这种乳牛一年可提取60-80千克促红生长素,比目前全世界的使用量还多。
风险
基因组药物的运用,将在医学上产生革命性的变化。药物将针对具体的每一个人,治疗效率变得更高,并且更省钱。”科学家这样告诉我们理解DNA。但我们距离那一天还很遥远。
《科学》杂志最近报道,科学家们乐观估计,要到2053年(DNA双螺旋结构发现100周年时),或者最乐观的估计是在2020年,才可能有基因组药物出现。
科学家一致认为,我们现在还没到达利用基因信息直接生产响应药物的地步。换言之,我们还没有跨入真正的基因时代。测试完成仅仅是开始“我们经常会碰到人们提问,当人类基因组序列测试完成的时候会怎样?以前通常的回答是:这将极大地促进药物的开发;预防性药物的时代即将来临;针对个人的疗法将得到推广;人类寿命将拉长。而现在我们已经知道,人类基因组序列测试的完成,其实仅仅是一个开始。”美国科学家新德里·波瑞纳说。
这种观点得到了中国科学家的认同。华大基因研究中心副主任、研究员谈学海说:“基因组药物的普遍应用当然是更为遥远的事。对人类整个基因组的认识、分析基因和各种疾病之间的关系都是巨大的工程,而让整个医学界跟上‘基因医学’的步伐更不是一朝一夕能够办到的事。”
“当人类和一些病原体基因工程部分完成的时候,有人认为在20年后,人类医药将发生翻天覆地的变化;一些顽强的人类健康杀手将得到有效的控制。但当我们庆祝DNA双螺旋分子结构发现50周年的时候,我们清楚地认识到,这样的认识很不成熟。”牛津大学分子药学学院的戴维德教授说。
如果我们人体生理学方面的知识没有取得决定性的进展,那DNA序列的测试将变得毫无意义。“我们必须了解,生病的时候,人体内部发生了怎样的变化,我们要怎样去干预、治疗以及预防。对于未来的药物,我们需要扎实的知识和信息来分析基因和各种疾病之间的关系,至少对于一些常见病需要能够弄清楚这些关系;此外,我们还需了解一些外在因素对疾病的影响。”
科学家认为,在未来,更多情况下障碍还是来自生物的多样性,即不同的人种带来的差异问题。
大概在30年前,医生开始使用一种强力杀死细胞的药物来治疗患白血病的儿童。这种叫做6-巯基嘌呤(6MP)的药物拯救了成千上万的生命。然而,这种药物会产生一定的副作用。早在20多年前就已经研究发现,它的毒素能够滞留病人体内,并且会遗传。这种药物能够迅速积累,然后渗入骨髓,进而产生感染。
不同的人种,这种酶缺陷的人所占比例是不一样的。例如,在高加索人中,每300个人中就有一个这样的人,这样的人是不能接受6MP治疗的,否则会带来致命的危险。
这种困惑将是未来的基因组药物普遍遇到的问题,基因药物的风险是肯定的。
基因兴奋剂

-
Taxus药物释放冠脉支架系统
2025-11-03 22:46:24 查看详情


 求购
求购







